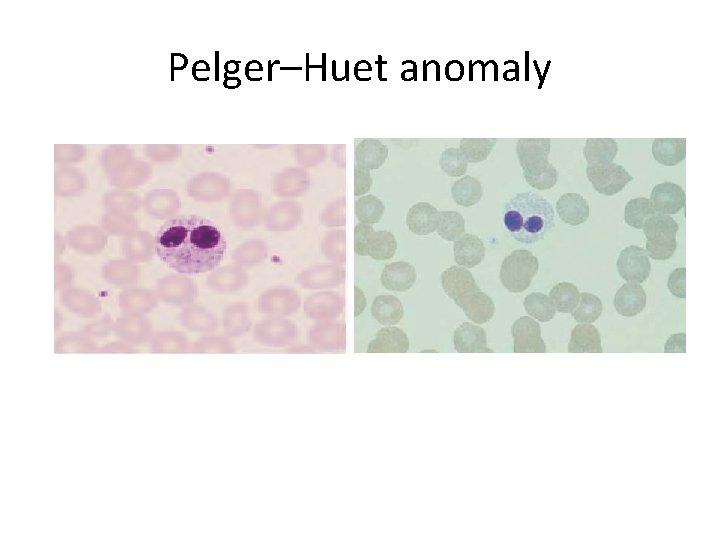
Pelger–Huet anomaly
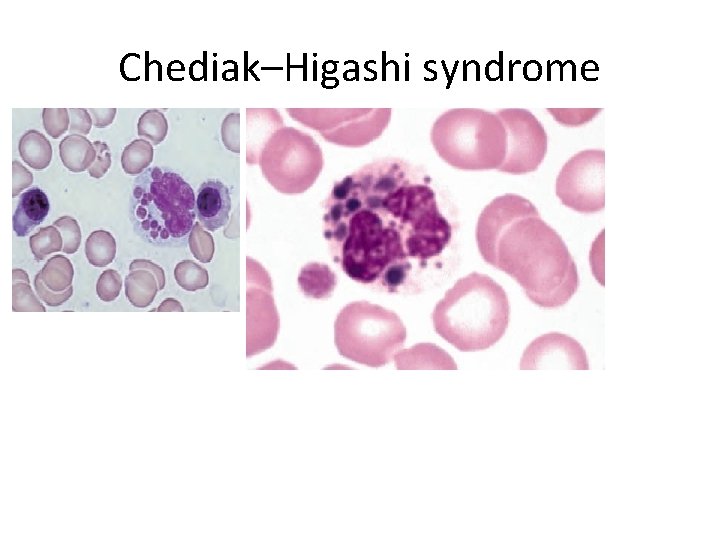
Chediak–Higashi syndrome
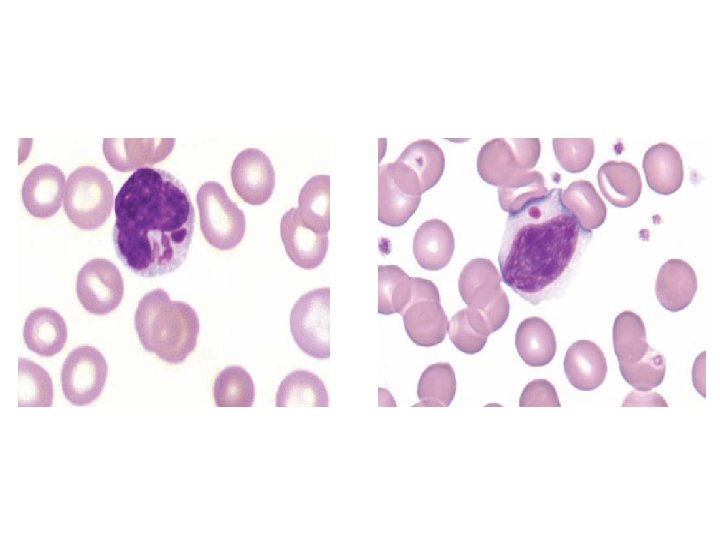
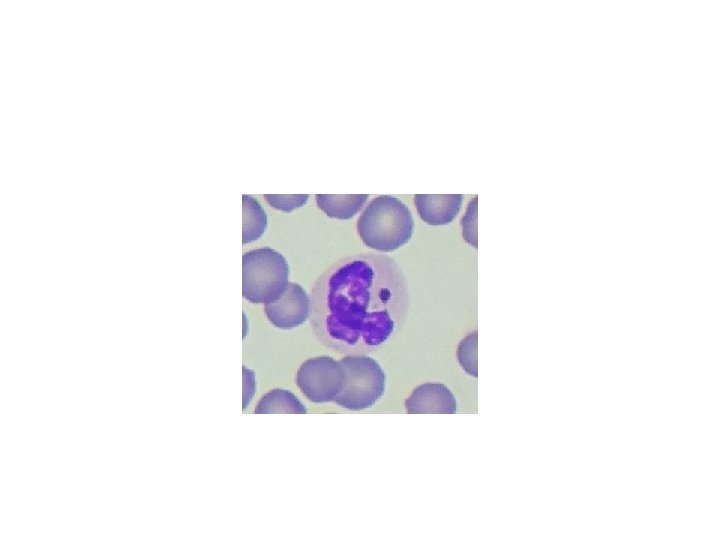

The white cells granulocytes monocytes and their benign

The white cells : granulocytes, monocytes and their benign disorders Assist. Prof. : Dr. Maysem Mouayad Alwash Assist. Prof. :

WBCs: Phagocytes: 1 -granulocytes: A‐neutrophils B‐eosinophils C‐basophils 2 -Monocytes. & Lymphocytes


• Phagocytes comprise the cells of the innate immune system. • Lymphocytes mediate the adaptive immune response • The function of phagocytes and lymphocytes in protecting the body against infection is closely connected with two soluble protein systems of the body: immunoglobulins and complement. .


Granulocytes Neutrophil (polymorph) • ‐a characteristic dense nucleus consisting of between two and five lobes. • ‐ a pale cytoplasm with an irregular outline containing many fine pink–blue (azurophilic) or grey–blue granules. The granules are lysosomal in origin. • The lifespan of neutrophils in the blood is only 6– 10 hours

• The granules are divided into : • Primary, which contains myeloperoxidase and other acid hydrolases; appear at the promyelocyte stage. • secondary contains lactoferrin, lysozyme and other enzymes , appear at the myelocyte stage and predominate in the mature neutrophil.

Neutrophil precursors • These do not normally appear in normal peripheral blood but are present in the marrow. • 1 -The myeloblast : the earliest recognizable precursor, a cell of variable size which has a large nucleus with fine chromatin and usually two to five nucleoli. The cytoplasm is basophilic and no granules are present. The normal bone marrow contains up to 5% of myeloblasts.

• 2 -Promyelocytes which are slightly larger cells and have developed primary granules in the cyto plasm. • 3 -Myelocytes : have specific or secondary granules. The nuclear chromatin is now more condensed and nucleoli are not visible. Separate myelocytes of the neutrophil, eosinophil and basophil series can be identified.

• 4 -Metamyelocytes: nondividing cells, which have an indented or horseshoe‐shaped nucleus and a cytoplasm filled with primary and secondary granules. 5 -‘band’, ‘stab’ or ‘juvenile: Neutrophil forms between the metamyelocyte and fully mature neutrophil. • These cells may occur in normal peripheral blood. • They do not contain the clear, fine filamentous distinction between nuclear lobes that is seen in mature neutrophils.

The formation of the neutrophil and monocyte phagocytes. Eosinophils and basophils are also formed in the marrow in a process similar to that for neutrophils .

Eosinophils These cells are similar to neutrophils, except that the cytoplasmic granules are coarser and more deeply red staining and there are rarely more than three nuclear lobes. • . The blood transit time for eosinophils is longer than for neutrophils. • They play a role in local immunity and tissue repair, special role in allergic responses, defence against parasites and removal of fibrin formed during inflammation

Basophils • These are only occasionally seen in normal peripheral blood. • They have many dark cytoplasmic granules which overlie the nucleus and contain heparin and histamine. • In the tissues they become mast cells. • They have immunoglobulin E (Ig. E) attachment sites and their degranulation is associated with histamine release

Monocytes ‐These are usually larger than other peripheral blood leucocytes. ‐possess a large central oval or indented nucleus with clumped chromatin. ‐The abundant cytoplasm stains blue and contains many fine vacuoles, giving a groundglass appearance. Cytoplasmic granules are also often present. The monocyte precursors in the marrow are monoblasts and promonocytes.

Monocytes spend only a short time in the marrow and, after circulating for 20– 40 hours, leave the blood to enter the tissues where they mature and carry out their principal functions. Their extravascular lifespan after their transformation to macrophages (histiocytes) may be as long as several months or even years

Granulopoiesis Granulocytes and monocytes are formed in the bone marrow from a common precursor cell.

In the granulopoietic series progenitor cells, myeloblasts, promyelocytesand myelocytes form a proliferative or mitotic pool of cells the metamyelocytes, band segmented granulocytes make up a post‐mitotic maturation compartment

• Reserve pool: Large numbers of band pool: segmented neutrophils (10– 15 times more than in the blood) are held in the bone marrow. In the bloodstream there are two pools usually of about equal size: the circulating pool (included in the blood count) and a marginating pool (not included in the blood count).


• The bone marrownormally contains more myeloid cells than erythroid cells, the largest proportion being neutrophils and metamyelocytes. Following their release from the marrow, granulocytes spend only 6– 10 hours in the circulation before entering tissues where they perform their phagocytic function. They spend on average 4– 5 days in the tissues before they are destroyed during defensive action or as the result of senescence.

Control of granulopoiesis: myeloid growth factors The growth factors stimulate proliferation and differentiation and also affect the function of the mature cells on which they act (e. g. phagocytosis, superoxide generation and cytotoxicity in the case of neutrophils). They also inhibit apoptosis. Many growth factors are involved in this maturation process including interleukin‐ 1 (IL‐ 1), IL‐ 3, IL‐ 5 (for eosinophils), IL‐ 6, IL‐ 11, granulocyte – macrophage colony‐stimulating factor (GM‐CSF), granulocyte CSF (G‐CSF) and monocyte CSF (M‐CSF)

Increased granulocyte and monocyte production in response to an infection is induced by increased production of growth factors from stromal cells and T lymphocytes, stimulated by endotoxin, and cytokines such as IL‐ 1 or tumour necrosis factor (TNF).


Disorders of neutrophil and monocyte function Defects of phagocytic cell function: -- Chemotaxis: ‐Congenital abnormalities rare e. g. ‘lazy leucocyte’ syndrome. ‐Acquired abnormalities : more common , either of the environment e. g. corticosteroid therapy or of the leucocytes themselves e. g. in acute or chronic myeloid leukaemia, myelodysplasia and the myeloproliferative syndromes.

• Phagocytosis: These defects usually arise because of a lack of opsonizationwhich may be caused by congenital or acquired causes of hypogammaglobulinaemia or lack of complement components

• Killing: ‐Congenital : rare a‐X‐linked or autosomal recessive chronic granulomatous disease that results from abnormal leucocyte oxidative metabolism. The patients have recurring infections, usually bacterial but sometimes fungal, which present in infancy or early childhood. b. myeloperoxidase deficiency c. Chediak–Higashi syndrome

• Acquired: Acute or chronic myeloid leukaemia and myelodysplastic syndromes may also be associated with defective killing of ingested microorganisms

Disorders in granulocyte morphology -Pelger–Huët anomaly ‐uncommon symptomless condition. ‐ bilobed neutrophils in the peripheral blood – ‐ Occasional unsegmented neutrophils are also seen. ‐ Inheritance is autosomal dominant.
Pelger–Huet anomaly

• Pseudo- or Acquired Pelger-Huët Anomaly ‐hematologic malignancies such as myelodysplastic syndromes (MDS), acute myeloid leukemia, and chronic myeloproliferative neoplasms. ‐HIV infection ‐Tuberculosis. ‐Mycoplasma pneumoniae and severe bacterial infections. ‐Drugs : mycophenolate mofetil, valproate, sulfisoxazole, ganciclovir, ibuprofen, and chemotherapies such as paclitaxel and docetaxel

May–Hegglin anomaly ‐rare condition. ‐the neutrophils contain basophilic inclusions of RNA (resembling Dohle bodies) in the cytoplasm. ‐There is an associated mild thrombocytopenia with giant platelets. ‐Inheritance is autosomal dominant.

May–Hegglin anomaly

Chediak–Higashi syndrome is inherited in an autosomal recessive manner, There are giant granules in the neutrophils, eosinophils, monocytes and lymphocytes, accompanied by neutropenia, thrombocytopenia and marked hepatosplenomegaly.
Chediak–Higashi syndrome

Neutrophil Hypersegmentation Normal neutrophils contain three to five lobes that are separated by filaments. ‐Hypersegmented neutrophils have more than five lobes and are seen in: ‐ most often associated with the megaloblastic anemias, where the neutrophil is also larger than normal -myelodysplastic syndromes ‐Hereditary neutrophil hypersegmentation: patients are asymptomatic and have no signs of megaloblastic anemia.


• Alder’s anomaly: coarse violet granules in the cytoplasm of a neutrophil.

A ‘drumstick’ (Barr body) appears on the nucleus of a proportion of the neutrophils in normal females and is caused by the presence of two X chromosomes

• Shift to the left in the peripheral blood differential white cell count : presence of immature neutrophils( an increase in the number of band forms and the occasional presence of more primitive cells such as metamyelocytes and myelocytes)

Neutrophil reaction to infection, inflammation, stress, or administration of recombinant colony‐stimulating factor (CSF) therapy may affect the number and types of circulating neutrophils (left shift), induce morphologic change, or both. While these changes may be considered “abnormal, ” they usually reflect a normal, reactive response. Depending on the severity of the infection, inflammation, or dose/reaction to CSF, the left shift can range from mild (an increase in band neutrophils and metamyelocytes) to moderate (metamyelocytes, and an occasional promyelocyte) to marked (myelocytes, promyelocytes, and an occasional blast form).

Reactive morphologic changes in neutrophils include toxic granulation, Döhle bodies, cytoplasmic vacuoles, hypersegmentation, and pyknosis.

Toxic granulation of neutrophils appears as dark, blue‐black granules in the cytoplasm of neutrophils: segmented, bands, and metamyelocytes. Toxic granulation, especially when intense, can mimic the granulation found in Alder‐Reilly anomaly. One helpful defining characteristic of toxic granulationis that in most patients not all neutrophils are equally affected

Toxic granulation Note that one neutrophil contains toxic granulation and the other does not. Also note that the toxic granules are clustered in some areas of the cytoplasm. Both of these findings help in distinguishing toxic granulation from poor staining or from the dark granules seen in Alder-Reilly anomaly.


- Slides: 47